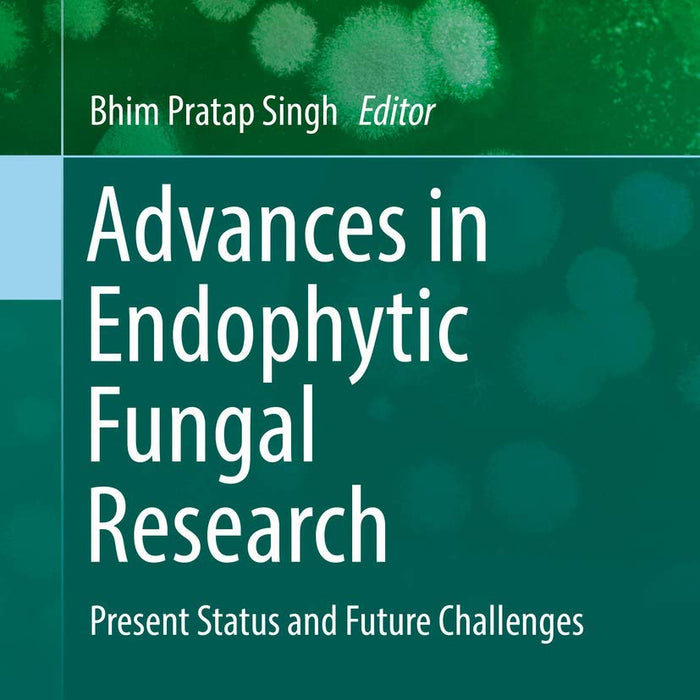
Advances in Endophytic Fungal Research: Present Status and Future Challenges Advances in Endophytic Fungal Research: Present Status and Future Challenges

Advances in Endophytic Fungal Research by Bhim Pratap Singh (Editor)
- Publisher: BIOLOGY
- Availability: In Stock
- SKU: 49170
- Number of Pages: 379
Rs.860.00
Rs.995.00
Tags: Advances in Endophytic Fungal Research , agricultural biotechnology , agricultural fungal research , best books , Best Price , Best Selling Books , Bhim Pratap Singh , bioprospecting fungi , biotechnological applications of fungi , challenges in fungal research , ecological impact of endophytes , ecological roles of endophytes , endophyte bioactive compounds , endophyte biotechnology , endophytes and plant growth , endophytes in agriculture , endophytes in crop protection , endophytes in drug discovery , endophytes in plant defense , endophytes in sustainable agriculture , endophytic fungal diversity , endophytic fungi applications , endophytic fungi research , fungal biodiversity , Fungal Biology , fungal diversity in plants , fungal metabolites , fungal research , fungal symbiosis in plants , fungi in bioremediation , fungi in plant stress tolerance , future challenges in fungal research , medical uses of endophytic fungi , Online Bookshop , pharmaceutical uses of endophytes , plant biology and fungi , plant health and endophytes , plant-microbe interactions , plant-microbe symbiosis , Present Status and Future
📘 Title Name: Advances in Endophytic Fungal Research: Present Status and Future Challenges
✍️ Author: Bhim Pratap Singh (Editor)
Quality: Black White Pakistan Print
🔹 Introduction:
This book explores the latest developments in endophytic fungal research, focusing on their ecological, pharmaceutical, and agricultural significance. It highlights the current state of research while addressing future challenges in the field.
🔑 Key Points:
-
Comprehensive analysis of endophytic fungi and their role in plant health and ecosystems.
-
Discusses the potential biotechnological applications of endophytic fungi in agriculture and medicine.
-
Provides insight into the challenges and opportunities in advancing endophytic fungal research.